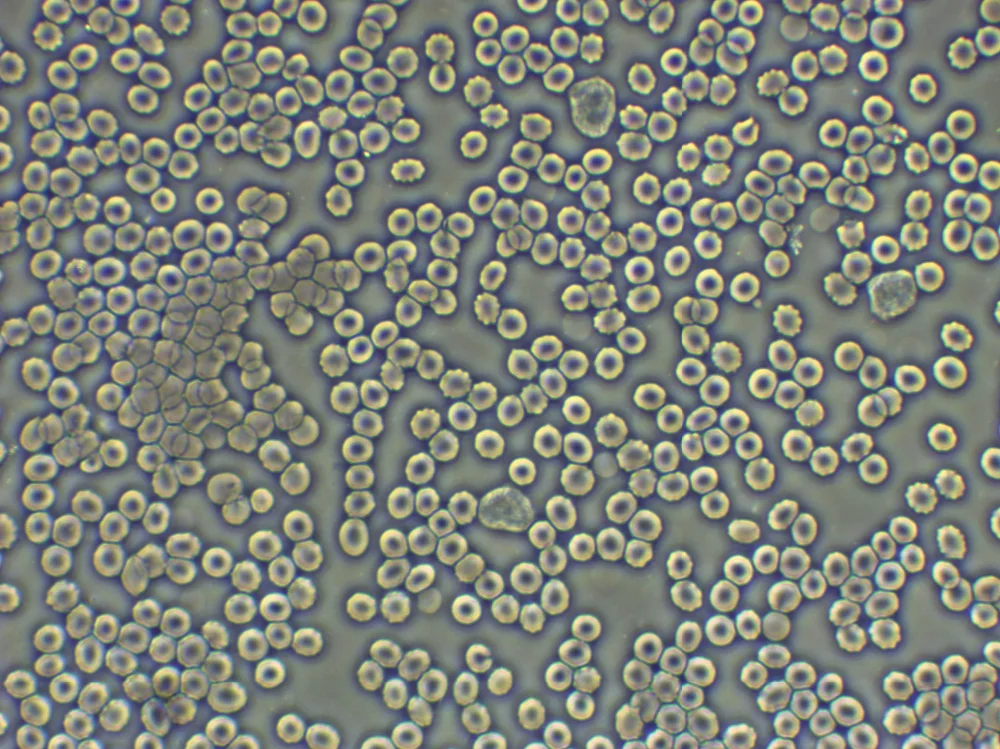

BLM-280 ЖК-цифровой Биологический микроскоп 1000X 8 дюймов
- Категория: Микроскопы >>>
- Поставщик: Beijing,Bestscope,Technology,Co.,Ltd.,[Beijing,China]Beijing
Поделиться:
Описание и отзывы
Трекер стоимости
| Месяц | Минимальная цена | Макс. стоимость |
|---|---|---|
| Sep-16-2025 | 53790.94 $* | 56480.29 $* |
| Aug-16-2025 | 53338.13 $* | 56005.96 $* |
| Jul-16-2025 | 44750.8 $* | 46988.66 $* |
| Jun-16-2025 | 52434.15 $* | 55056.16 $* |
| May-16-2025 | 45654.29 $* | 47937.33 $* |
| Apr-16-2025 | 51530.96 $* | 54107.2 $* |
| Mar-16-2025 | 51078.88 $* | 53632.84 $* |
| Feb-16-2025 | 50626.46 $* | 53157.75 $* |
| Jan-16-2025 | 50174.53 $* | 52683.94 $* |
Характеристики
BLM-280 ЖК-цифровой Биологический микроскоп
Введение
BLM-280ЖК-цифровой микроскопМикроскоп нового поколения, который имеетAndroidСистема. С 8"С ЖК-дисплеемЭкран, работает какПланшетный ПК. Вы можете делать фотографии, снимать видео иЕсть лиИзмерение на машине. С дружественным интерфейсом man-machine, мощной функцией обработки (Предварительный просмотр в реальном времени, динамическая калибровка и измерение), простой в эксплуатации и удобный механический дизайн, это ваш лучший помощник в обучении, электронный осмотр, биологические и медицинские исследования!
По ногеЕ
1.BLM-280 цифровой ЖК-Микроскоп-микроскоп нового поколения с ОС Android,Так же, как планшетыПК.
2.Поддержка Wi-Fi беспроводной и синийЗуба.Это'Легко для того, чтобы продлить tHE приложения.
3.С 8 дюймов IPS ЖК-экран,Двухъядерный процессор A7 1,6G,Поддержка 5 точек касания,HD видео выход и sd-карта.
Применение
BLM-280 ЖК цифровой микроскоп может быть использован в университетах,ЛабораторийИ больницыДля обучения, биологических и медицинских исследований.
Спецификация
|
Предмет |
Спецификация |
BLM-280 |
|
Цифровая печать |
5. 0 мегапикселей CMOSДатчик |
♦ |
|
Поддержка Wi-Fi и Bluetooth |
♦ |
|
|
Смотровой головки |
Головка SeidentopfБесплатно бинокуляр,300Наклонный,360°Вращающийся,Межзрачковое48-75 мм |
♦ |
|
Окуляр микроскопа |
Широкий окуляр WF10×/18Мм |
♦ |
|
Широкий окуляр WF10×/20 мм |
& Loz; |
|
|
Цель |
Бесконечная полуплан ахроматическая цель 4×,10×,40×,100× |
♦ |
|
БесконечныйПлан ахроматическая 4×,10×,20×,40×,60×,100× |
& Loz; |
|
|
Дужкой |
Четырехместный дужкой |
♦ |
|
Сценический |
Двухслойный механический этап 140×140Мм, Движущийся диапазон:75×50Мм |
♦ |
|
CondensER |
Сползая в Центровой конденсаторER NA1.25 |
♦ |
|
Фокусировки |
Коаксиальный грубой и тонкой настройки, точное разделение 0,002 мм, грубый ход 37,7 мм на один оборот, точный ход 0,2 мм на один оборот, движущийся диапазон 20 мм |
♦ |
|
Подсветка |
6V/20W галогенная лампа освещения,ЯркостьРегулируемый |
& Loz; |
|
1 Вт S-Со светодиодным освещением, яркостьРегулируемый |
♦ |
|
|
Другие аксессуары |
Поляризационное крепление с поляризатором и анализатором |
& Loz; |
|
Фазовое контрастное крепление с 10X, 40X, 100X фазовым контрастным объективом |
& Loz; |
|
|
Насадка для темного поля сухая/масляная |
& Loz; |
|
|
Светодиодный экран |
8 дюймовIPSСенсорным экраном |
♦ |
|
Выход |
USB2.0,Мини USB,HD |
♦ |
|
OS |
Android 4.2.2 |
♦ |
|
Программное обеспечение |
Touchscope |
♦ |
|
SD карта |
Поддержка SD карты |
& Loz; |
|
Коврик для мыши |
Используется для управления планшетом |
& Loz; |
Примечание:Примечание:♦Стандартное обмундирование,& Loz;Опционально
Похожие товары
High Quality Binocular Microscopio Optical Microscope
Микроскоп для мобильного телефона
Данные ресурс не является интернет-магазином, а лишь содержит ссылки на международную торговую площадку Alibaba.com